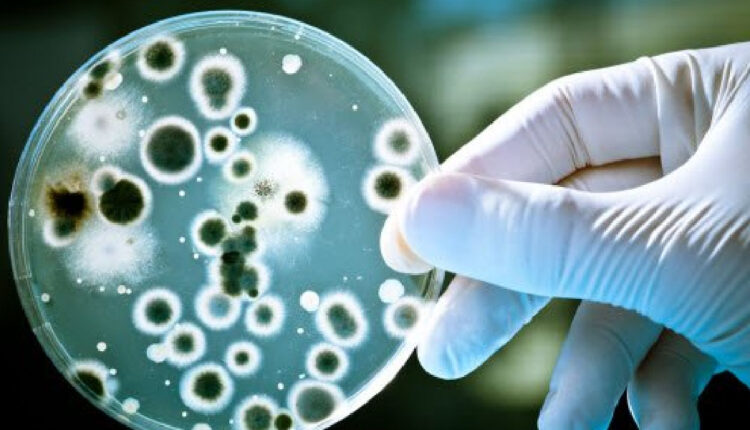

काठमाडौँ, ९ असार । राष्ट्रिय विपद् जोखिम न्यूनीकरण तथा व्यवस्थापन प्राधिकरणले काठमाडौँको बागबजारको धारा र ट्युबेलको पानीमा हैजा फैलाउने जीवाणु भेटिएको जनाएको छ ।
काठमाडौँमा हैजाका बिरामी भेटिएपछि बागबजारको धारा र ट्युबेलको पानीको परीक्षण गरिएको थियो । परीक्षण गर्दा पानीमा हैजा फैलाउने जीवाणु भेटिएको प्राधिकरणले जनाएको छ ।
‘हिजो बागबजारको धारा र ट्युबेलको पानीमा हैजा फैलाउने जीवाणु भेटियो । बर्खाको समयमा पानी प्रदूषित हुने जोखिम धेरै हुन्छ । पानी उमालेर वा शुद्धीकरण गरेर मात्र पिउने गरौँ,’ प्राधिकरणले सामाजिक सञ्जाल ट्वीटरमार्फत् सर्वसाधरणलाई सजग हुन भनेको छ ।